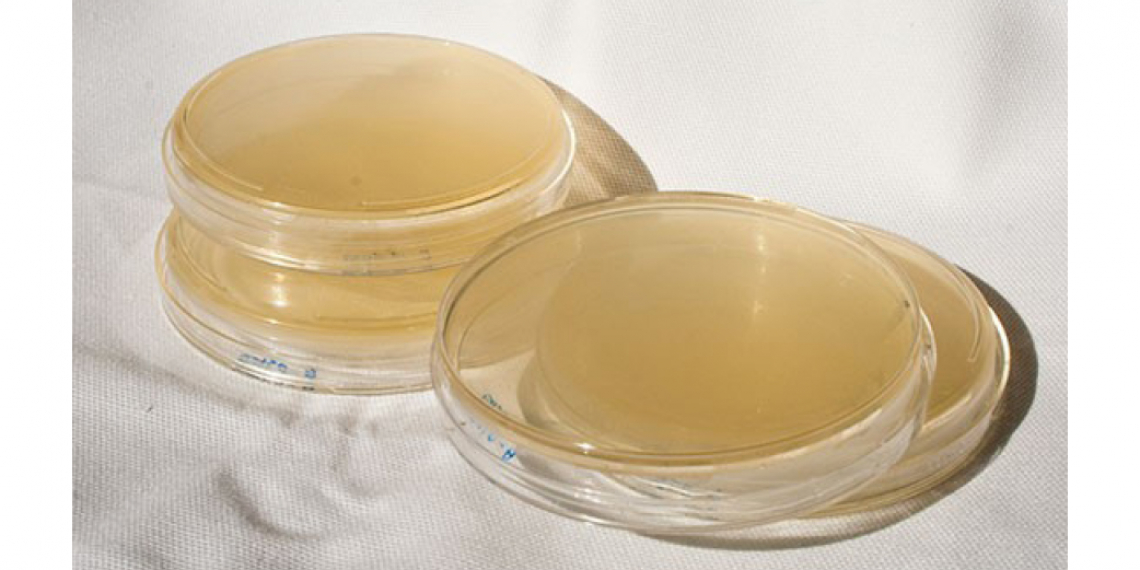

Agar is a mixture of polysaccharides widely used in food, chemical and pharmaceutical industries for its jelly-like structure. Among a variety of purposes, it can be used as a solid substrate for culture media, as a laxative, as a substituent to gelatine or as a preservative for fruits. As it is obtained from different species of red algae, it can be quality can vary from lot to lot.
This application note presents how and if NIR spectroscopy can be used to identify optimal and sub-optimal lots of powdered gelatine agar.